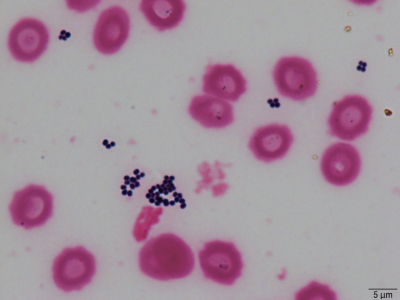
#

65歳の男性。食道癌手術後に入院中である。
現病歴:食道癌のため、10日前に胸腔鏡補助下胸部食道全摘術を施行した。術後経口摂取が困難と予想されたため、7日前に右内頸静脈に中心静脈カテーテルを留置して中心静脈栄養を開始した。以後徐々に経口栄養摂取は増加していた。今朝6時のバイタルサインには異常を認めず朝食時も問題なかったが、9時に医師が病室を訪ねると意識障害が認められた。
既往歴: 50歳から高血圧症に対して内服加療中。
生活歴: 昨年まで事務職。喫煙は20本/日を35年間。飲酒は機会飲酒。
家族歴: 両親が胃癌で死亡。
現症: 意識レベルはJCSⅡ-10、GCS E3V4M6。身長 167 cm、体重 48 kg。体温 38.5 ℃。脈拍 114/分、整。血圧 88/50 mmHg。呼吸数 24/分。SpO₂ 96 % (room air)。皮膚は湿澗している。眼瞼結膜は軽度貧血様である。眼球結膜に黄染を認めない。口腔内と咽頭に異常を認めない。中心静脈カテーテル刺入部に異常を認めない。心音と呼吸音とに異常を認めない。手術創に異常を認めない。腹部は平坦、軟で、肝・脾を触知しない。圧痛を認めない。背部の皮膚に異常を認めない。椎体の圧痛と叩打痛は認めず、また肋骨脊柱角の叩打痛は認めない。四肢は軽度の浮腫を認める。
検査所見: 尿所見:蛋白 (-)、糖 (-)、ケトン体 (-)、潜血(±)、沈渣に白血球を認めない。血液所見:赤血球 345万、Hb 10.2 g/dL、Ht 31%、白血球 17,300 (桿状核好中球 28%、分葉核好中球 47%、好酸球 1%、好塩基球 0%、単球 7%、リンパ球 17%)、血小板 16万、PT-INR 1.1 (基準 0.9-1.1)。血液生化学所見:総蛋白 6.0 g/dL、アルプミン 2.5 g/dL、総ビリルビン 1.0 mg/dL、AST 71 U/L、ALT 58 U/L、LD 402 U/L (基準 120-245)、ALP 330 U/L (基準 115-359)、γ-GT 48 U/L (基準 8~50)、CK 143 U/L (基準 30-140)、尿素窒素 25 mg/dL、クレアチニン 0.9 mg/dL、血糖 122 mg/dL、Na 134 mEq/L、K 4.1 mEq/L、Cl 97 mEq/L、Ca 8.0 mg/dL、P 4.2 mg/dL。CRP 24 mg/dL。動脈血ガス分析 (room air) :pH 7.45、PaCO₂ 34 Torr、PaO₂ 102 Torr、HCO₃⁻ 24.2 mEq/L。
この時点での quick SOFAスコア はどれか。
a. 0点
b. 1点
c. 2点
d. 3点
e. 4点
意識障害の原因として最も疑うべきものはどれか。
a. Clostridioides difficile腸炎
b. カテーテル関連血流感染症
c. 化膿性脊椎炎
d. 急性腎孟腎炎
e. 誤嚥性肺炎
2セットの血液培養を採取したところ、2セットとも培養陽性となった。培養ボトル内容液のGram染色標本を別に示す。
この微生物の同定および薬剤感受性試験の結果を待つ間に投与を開始しておくべき抗菌薬はどれか。
a. クラリスロマイシン
b. バンコマイシン
c. ペニシリンG
d. メロペネム
e. レボフロキサシン